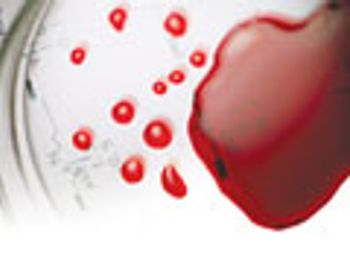

Sample preparation is a crucial part of the analysis of foodstuffs. Current sample preparation techniques used in food analysis are reviewed and the advantages and drawbacks of each one are discussed.

Sample preparation is a crucial part of the analysis of foodstuffs. Current sample preparation techniques used in food analysis are reviewed and the advantages and drawbacks of each one are discussed.

LC method development for new drug candidates or screening methods for new active structures in botanicals present the same type of challenges: How do I know that I have separated all main components, as well as important, sometimes hidden, impurities? Is my resolution good enough? Am I missing small, co-eluting peaks?

The current state of economic affairs is tumultous; as the economy struggles to bounce back, companies across all industries are becoming more creative in finding ways to reduce costs without sacrificing the quality of their goods or services. According to a recent survey conducted by the Society of Forensic Toxicologists (SOFT), 64.5% of forensic labs surveyed are implementing changes, or plan to implement changes, as a result of limited resources.

Turbulent flow chromatography is often used for on-line sample cleanup of biological matrices in liquid chromatography–mass spectrometry applications.

Part I of this series explains how lipids analysis has evolved.

Examples of a wide variety of sample preparation techniques for the analysis of trace-level contaminants in food and the advantages and disadvantages of each are discussed in this article.

Gathering information about the chemical and physical properties of target analytes is an essential step to effective solid-phase extraction (SPE) method development.

Sample preparation is the basis for all separations-related research.

Describes practical aspects of hollow-fibre liquid-phase microextraction in the three phase mode (HF3LPME) and also electromembrane extraction (EME).

A presentation of the overall trends in liquid-phase chromatography observed at the symposium, as well as the awards presented and the opening plenary session

Polymers are sensitive molecules. Depending on the polymer architecture or copolymer composition, it is possible to have bonds present along the polymer chain that can easily be broken.

Flash chromatography is a type of preparative liquid chromatography commonly used in the separation of organic compounds.

Aggregated singletons for automated purification workflow delivers 30 mM DMS solutions for biological screening.
Microextraction by packed sorbent is a sample preparation technique that can be connected on-line with LC or GC systems.

A review of the gas chromatography columns, sample preparation, and chromatographic and sample preparation accessories that were presented at Pittcon 2011.

The 2011 Dal Nogare award has been presented to Janusz Pawliszyn at Pittcon 2011.

Discussing the latest developments in sample preparation techniques that reduce environmental impact.

A review of the liquid chromatography columns and accessories for analytical and preparative chromatography to be unveiled at Pittcon 2011

Now in its fourth year, the LCGC Awards have quickly grown into one of the premier honors for both emerging and veteran practitioners of chromatography.

An overview of high-throughput process development (HTPD) tools and approaches, as well as a case study

This article focuses on two of the more common techniques applied to the analysis of a series of benzodiazepines in a biological matrix.

An introduction to sequential injection analysis as a useful tool for automated sample preparation.

A multistep workflow process provides purified samples for in-vitro testing in just two or three business days.

High recovery, reproducibility, and cost savings are among the advantages of this environmentally friendly method.

Miniaturization and solvent substitution are two key approaches.